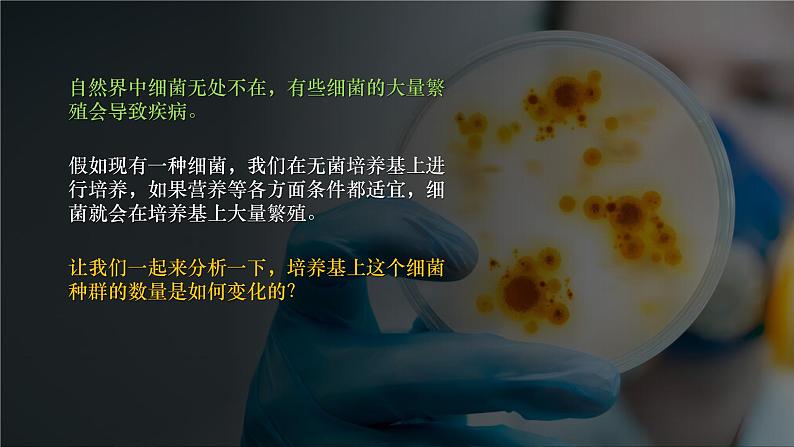

所属成套资源:【中学生物科学】人教版2019高中生物选择性必修2《生物与环境》课件PPT
高中生物人教版 (2019)选择性必修2第2节 种群数量的变化完美版课件ppt
展开
这是一份高中生物人教版 (2019)选择性必修2第2节 种群数量的变化完美版课件ppt,共60页。PPT课件主要包含了水葫芦的危害,理想条件,环境阻力,为什么,资源空间有限,种群数量的波动,抽样检测法,血细胞计数板等内容,欢迎下载使用。
近年来,水葫芦在我国淡水河道密集地区不断疯长,已成为令人头疼的河网“杀手”,并严重影响了河道的景观。
为什么水葫芦会增长的如此迅猛?
如何防治水葫芦的过度增长?
为有效控制生物的种群数量,我们需要了解种群数量的变化规律
建构种群增长模型的方法
The methd f cnstructing ppulatin grwth mdel
假如现有一种细菌,我们在无菌培养基上进行培养,如果营养等各方面条件都适宜,细菌就会在培养基上大量繁殖。
让我们一起来分析一下,培养基上这个细菌种群的数量是如何变化的?
自然界中细菌无处不在,有些细菌的大量繁殖会导致疾病。
假设在营养和生存空间没有限制的情况下,某种细菌每20 min就通过分裂繁殖一代。
第n代细茵数量的计算公式是什么?
假设细菌种群起始数量是1
第n代细菌数量的计算公式:
假设细菌种群起始数量是N0
不能,这个公式建立的前提条件是营养和生存空间没有限制。
这个计算公式能不能运用于所有细菌?公式建立的前提条件是什么?
以时间为横坐标,细菌数量为纵坐标,画出细菌种群的增长曲线。
思考:这样曲线图和它所对应的数学公式相比有什么优势?又有什么不足?
在这个过程中,我们已经运用数学模型来分析细菌种群的数量变化,那么,什么是数学模型呢?
mathematical mdel
用来描述一个系统或它的性质的数学形式
数学模型当前已广泛应用于自然科学和社会科学的各个领域,并发挥着十分重要的作用。
新冠肺炎疫情期间,有不少科技人员根据各类数据,并利用数学建模预测疫情拐点,为打赢这场疫情防控阻击战提供了有力科技支撑。
通过大量观察和实验得出“细菌每20分钟分裂一次”的规律
提出问题“怎样计算细菌繁殖n代后的数量?”
将生物学问题转化为数学问题
提出合理的假设。这是数学模型成立的前提条件
假设不同,所建立的数学模型也不相同
假设:在资源和空间无限多的环境中,细菌种群的增长不会受种群密度增加的影响
对研究的问题用数学形式来表达,也就是数学模型的表达形式。
根据实验数据,分裂n代后的细菌种群数量可以表达成数学公式:Nn=N0×2n
Nn:n代后的种群数量N0:种群的起始数量2:细菌每一代都是上一代数量的两倍n:代数
对模型进行检验和修正,在科学研究中是必不可少的步骤。
通过进一步观察和实验,对建立的模型进行检验或修正
真理应该是经得起实践的检验的
以上讨论的是在实验条件下种群的数量变化,在自然界中种群的数量变化情况如何?我们一起来看看几个实例。
野兔种群为什么能在近百年间,快速增长?
生存条件适宜(气候、食物、无天敌)
1859年,一位英国人来到澳大利亚定居,他带来了24只野兔。让他没有想到的是,一个世纪之后,这24只野兔的后代竟达到6亿只以上。漫山遍野的野兔与牛羊争食牧草,啃啮树皮,造成植被破坏,导致水土流失。后来,人们引入了黏液瘤病毒才使野兔的数量得到控制。
这两个资料中种群增长有什么共同点?
种群数量增长迅猛,且呈无限增长趋势。
在20世纪30年代,人们将环颈雉引入美国的一个岛屿。在1937-1942年期间,这个种群数量的增长如右图所示。
种群出现这种增长的原因是什么?
食物充足,缺少天敌等。
环颈雉种群数量变化曲线大致呈什么型?
种群的 “J” 形增长
"J" shaped grwth f ppulatin
食物和空间条件充裕气候适宜没有天敌和其他竞争物种等
例如:人工控制的实验室理想条件、刚迁入一个适宜的新环境的种群(外来物种入侵的早期)等
t:代数Nt:t代后的种群数量 N0:起始数量λ:每一代种群数量是前一代的倍数
λ表示该种群数量是前一年种群数量的的倍数
11-12年下降,12-13年增长
“J”型增长能一直持续下去吗?
在一个培养瓶中,细菌的数量会一直按照公式Nn=N0×2n描述的趋势增长吗?
自然界存在着很多限制种群数量增多的因素。比如食物是有限的,气候也不一定是非常合适,还有天敌的存在等等。
在自然界中,种群不能无限制地增长。因为,随着种群数量的增长,制约因素的作用也在增大,所以种群总是在增长到一定限度后达到相对稳定。
大草履虫的种群增长曲线大致呈什么型?
生态学家高斯把5个大草履虫置于0.5mL的培养液中,每隔24小时统计一次数据,经过反复实验,得出了如下右所示的结果
你认为大草履虫种群数量变化呈S型曲线的原因是什么?
0.5 mL培养液,空间和营养都是有限的
为什么大草履虫第二天、第三天增长较快,而第五天以后数量基本稳定?
培养初期草履虫种群数量少,空间和资源相对丰富,所以初期增长快。随着草履虫种群数量的增长,空间和资源相对不足,所以后期增长速率下降,最终趋向稳定。
从图中可以看出,大草履虫的数量在第2天和第3天增长较快,第五天以后基本保持在375个左右
在高斯实验的基础上,如果要进一步搞清是空间的限制,还是资源(食物)的限制,该如何进行实验设计?
进行对照实验准备三组实验
第二组:其他条件和第一组相同,增大草履虫的培养容器
第一组:高斯实验作为第一组
第三组:其他条件和第一组相同,培养过程中,不断添加草履虫食物
种群的 “S” 形增长
"S" shaped grwth f ppulatin
种群密度增大,种内竞争加剧,种群出生率降低,死亡率升高。当死亡率和出生率相等时,种群的增长停止,稳定在一定水平。
空间和资源相对丰富,所以初期增长速率快
后期由于空间和资源相对不足,增长速率下降,最终趋向稳定。
环境容纳量:在环境条件不受破坏的情况下,一定空间中所能维持的种群最大数量。
在环境条件不受破坏的情况下,一定空间中所能维持的种群最大数量。
湿润草原和干旱草原,羊群的K值相同吗?
①同一种群的K值不是固定不变的,会受到环境的影响。
同一片草场,鼠群和牛群的K值相同吗?
②同一环境,不同种群的K值不同。
生物自身的遗传特性和环境条件均会影响环境容纳量。
● 在环境不遭受破坏的情况下, 种群数量会在K值上下波动。当种群数量偏离K值的时候,会通过负反馈调节使种群数量回到K值。
● 在环境遭受破坏后,种群数量下降,并在新的K值上下波动。
国宝大熊猫由于栖息场所遭到破坏后,由于食物的减少和活动范围的缩小,这是大熊猫种群数量锐减的重要原因。
思考:保护大熊猫的根本措施是什么?
建立自然保护区,改善栖息环境,从而提高环境容纳量
保护有益生物的根本措施:提高环境容纳量(K值)
思考:控制鼠群数量有哪些思路和对应具体措施?
采取措施降低有害动物种群的环境容纳量的方法。
①将食物储藏在安全处,断绝或减少它们的食物来源②室内采取硬化地面等措施,减少它们挖造巢穴的场所③养殖或释放它们的天敌等等
防治有害生物的根本措施:降低环境容纳量(K值)
K/2值(K值的一半)
此时种群的增长速率达到最大
种群增长速率低,数量不易恢复
种群数量下降,增长速率反而上升,数量能较快恢复
K/2值在实践中的应用
思考:为了保护鱼类资源不受破坏,并能持续地获得最大捕鱼量,应使被捕鱼群的种群数量保持在什么水平?为什么?
有益生物的利用:种群数量维持在K/2以上
如果大肆捕捞,使鱼类数量大为减少,降到了K/2值以下,会引起种群在相当长的时间才会达到快速生长期,对生产极为不利。为了实现可持续发展的目的,捕捞应该选择在K/2值以上。
最大捕获量:是遵循可持续原则,长久而言捕获的最大量。当种群达到K/2时,种群增长速率最大,因此让种群数量保持在K/2,种群可以迅速恢复到K值供下次捕获。
最大日捕获量:是一天内能捕获的最大数量,应在种群密度最大时。当种群数量达到k时,该点切线斜率接近于零,也就是增长速率接近于零,此时种群数量达到最大值,可以获得最大日捕获量。
思考:在控制鼠害过程中,如果仅仅采用捕鼠器或老鼠药来减少老鼠的数量,往往效果不能持久,为什么?
防治老鼠中,如果毒杀约一半的老鼠,而活下来的老鼠数量正相当于其种群指数生长期(K/2)的数量,老鼠数量将迅速增长并快速的恢复到原有的水平。因此,应该将老鼠的数量控制在K/2以下才行。
有害生物的防治:控制种群数量在K/2以下
t0 t1 t2
自然界的多数种群都是以“S”型曲线增长的,
当种群数量达到K值以后,
种群数量是否就能够一直维持稳定?
Fluctuatin f ppulatin quantity
有的种群能够在一段时期内维持相对稳定
非洲草原上的野牛、狮种群数量相对稳定
提示:相对稳定不是恒定不变
多数种群,数量总是在波动中
某地区东亚飞蝗种群数量在1913-1961年一直处于不规则的波动状态
遭遇人类乱捕滥杀和栖息地破坏
种群的延续需要有一定的个体数量为基础
种群数量过少会引起衰退或消亡
对于低于种群延续所需要的最小种群数量的物种,需要采取有效的保护措施。
1.判断下列表述是否正确(1)“J”形曲线是发生在自然界中最为普遍的种群增长模式 ( )(2) 外来入侵物种进入一个新环境,其种群数量一定表现为“J”型增长 ( )(3) 年龄组成若为增长型,则种群数量必将增加 ( )(4) 种群数量达到K值以后,种群受食物、空间等因素的限制,增长速率为零,种群数量不再发生变化 ( )(5) 呈“S”型增长的种群,随着种群数量的增加,环境阻力不断增大 ( )
2.下图表示出生率、死亡率和种群密度的关系,据此正确是( ) A.在K/2时控制有害动物最有效 B.图示规律也可作为控制人口增长的依据 C.该图可用于实践中估算种群最大净补充量 D.在K/2时捕捞鱼类最易得到最大日捕获量
3.某岛屿引入外来物种野兔,研究人员调查了30年间野兔种群数量的变化,并据此绘制了λ值的变化曲线图,以下叙述正确的是:( ) A.第1年至第5年间野兔种群数量保持稳定 B.第5年起野兔种群数量开始下降 C.第15年至第20年间野兔种群数量呈“J”型增长 D.第20年至第30年间野兔种群数量增长率为0
探究:培养液中酵母菌种群数量的变化
Explratin: change f yeast ppulatin in culture medium
生长周期短,增殖速度快
无氧呼吸 能产生酒精,常用于酿酒和做面包
酵母菌是一种单细胞真核生物,生长周期短,增殖速度快,属于兼性呼吸型生物,有氧呼吸产生水和二氧化碳,无氧呼吸能产生酒精,因此常用于酿酒和做面包。
有氧呼吸 产生水和二氧化碳
可以用液体培养基来培养
Ask questins
培养液中酵母菌的数量是怎样随时间变化的?
Make assumptins
培养液中的酵母菌数量一开始呈“J”形增长;随着时间的推移, 酵母菌数量呈“S”形增长。
Experimental design
怎样对酵母菌进行计数?
一种常用的细胞计数工具,医学上常用来计数红细胞、白细胞等而得名,也常用于计算一些细菌、真菌、酵母等微生物的数量。
Bld cell cunting bard
一种常用的细胞计数工具
由优质厚玻璃制成的长方形玻璃板
中间部分被“H”型凹槽分为上下两个相同的计数平台
每个计数平台由9个大方格组成
长和宽各为1mm,深度为0.1mm即1mm×1mm×0.1mm其容积=0.1mm3,即0.1 μL
大方格(容积0.1mm3)
中央的大方格又称为计数室
大方格内分为25中方格中方格内分为16小方格即 25 × 16 型=400小格
大方格内分为16中方格中方格内分为25小方格即 16 × 25型=400小格
总容积:0.1mm3小格:400格每小格容积:0.1/400 mm3
酵母细胞个数/mL =
某小组进行“探究培养液中酵母菌种群数量的变化”实验,利用血细胞计数板(25×16型)对酵母菌进行计数。取1 mL培养液加9 mL无菌水,若观察到所选5个中方格内共有酵母菌80个,则培养液中酵母菌的种群密度为_____________
【解析】5个中方格(共80个小方格)内共有酵母菌80个,则酵母菌密度=80×5万=400万(个/mL)=4×106(个/mL)。又因为酵母菌样品稀释了10倍,又因为酵母菌样品稀释了10倍,因此上述1 mL酵母菌样液中约有菌体=400万×10=4×107(个/mL)
4×107(个/mL)
取清洁无油的血细胞计数板,在计数室上面加盖玻片
用吸管吸取培养液,滴于盖玻片边缘,让培养液自行渗入到计数室内。
静置数分钟,待酵母菌细胞全部沉降到计数室底部,将计数板放在在载物台中央,计数一个小方格内酵母菌数量
从试管吸取培养液进行计数之前,为什么要将试管轻轻振荡几次?
使菌体分散开来、混和均匀,减少实验误差
用血细胞计数板进行计数时,为什么先盖盖玻片,再加培养液?
先盖盖玻片,再从盖玻片边缘滴加酵母菌培养液,以防气泡产生
为何要待酵母菌全部沉降到计数室底部再计数?
因为计数室中的菌悬液有一定的高度(0.1mm),需要让细胞沉降到计数室底部的网格线中,避免细胞分布在不同液层深度,导致计数时被遗漏。
如果一个小方格内酵母菌数过多难以数清,应采取怎样的措施?
对于压在小方格界限上的酵母菌,应当如何计数?
计上不计下,计左不计右
实验需要设置对照吗?为什么?
不需要,酵母菌每天的数量变化可形成前后对照
需要,计数时取多个方格求平均值
experimental result
酵母菌种群数量统计 (单位:105个/mL)
experimental vide
一、建构种群增长模型的方法
一般步骤: ①提出问题→②作出假设→③建构模型→④检验修正
● 有的种群能够在一段时期内维持相对稳定
● 多数种群,数量总是在波动中
● 爆发增长、持续或急剧下降
● 种群的延续需要有一定的个体数量为基础
● 对于低于种群延续所需要的最小种群数量的物种,需要采取有效的保护措施。
四、探究:培养液中酵母菌种群数量的变化
因变量:酵母菌种群数量
①准备→②接种→③培养→④计数
相关课件
这是一份高中第1章 种群及其动态第1节 种群的数量特征精品课件ppt,共60页。PPT课件主要包含了种群的数量特征,逐个计数法,估算法,适用范围,数量较少的濒危生物,黑光灯诱捕法,样方法,标记重捕法,③标志物不能过于醒目,头公顷等内容,欢迎下载使用。
这是一份人教版 (2019)选择性必修2第1章 种群及其动态第1节 种群的数量特征完整版课件ppt,共60页。PPT课件主要包含了生命系统结构层次,种群的数量特征,出生率死亡率,种群密度,迁入率迁出率,年龄组成,性别比例,年龄结构等内容,欢迎下载使用。
这是一份高中人教版 (2019)第2节 内环境的稳态试讲课课件ppt,共51页。PPT课件主要包含了PartOne,内环境的动态变化,外界环境,体内细胞,内环境稳态,对稳态调节机制的认识,PartTwo,PartThree,内环境稳态的重要意义,PartFour等内容,欢迎下载使用。









